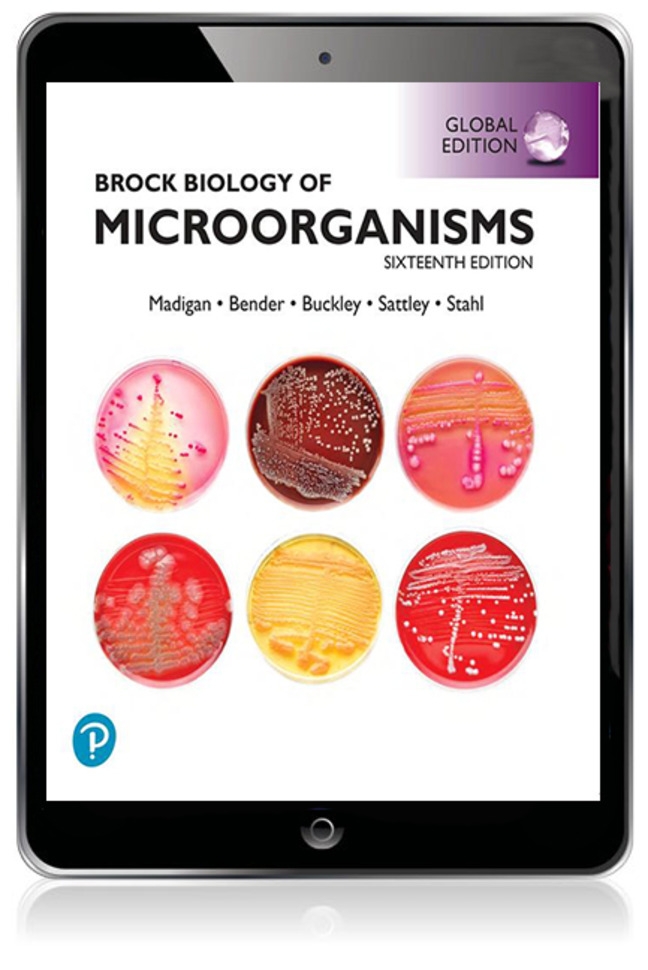

Brock Biology of Microorganisms, Global Edition
Provide your students with a solid understanding of the major concepts in microbiology.
Brock Biology of Microorganisms, Global Edition, 16th Edition is the latest version of this leading textbook in the field.
By expanding on art programs and powerful resources, this edition ensures that your students experience microbiology as a visual science.
- Buch 90,42 €
- eBook (Kortext ePub) 58,10 €
- Interaktives eTextbook / 6 Monate 38,24 €
- Interaktives eTextbook / 60 Monate 58,05 €
- eBook (Kortext PDF) 58,10 €
Produktdetails
Artikelbeschreibung
Get a solid understanding of the major concepts in microbiology with a textbook t hat offers cutting-edge research findings, powerful tools, and visuals.
Brock Biology of Microorganisms, Global Edition, 16th Edition is the latest version of the most authoritative textbook in the field, offering powerful, accurate, yet accessible content surrounding the basic concepts of microbiology.
The text guides you through the six major themes of microbiology — Evolution, Cell Structure and Function, Metabolic Pathways, Information Flow and Genetics, Microbial Systems, and the Impact of Microorganisms — as outlined by the American Society for Microbiology Conference on Undergraduate Education (ASMCUE).
Following a modern robust approach, the book supports your knowledge of the genomics and other omics" maze - concepts that are fundamental to the field and have transformed and revolutionised microbiology. Furthermore, it provides concrete examples of how powerful tools have allowed microbiologists to probe deeper and further into the microbial world than ever before.